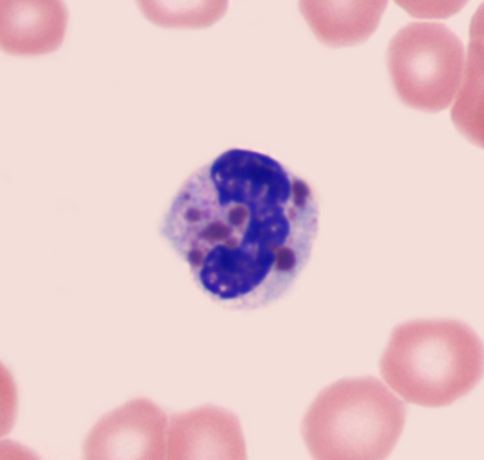

A) Extensive pulmonary fibrosis
B) Impaired immunoglobulin G response
C) Impaired macrophage function
D) Impaired type 2 helper T cell function
E) Ineffective mucociliary clearance
G) A) and D)
Correct Answer

verified
Correct Answer
verified
Multiple Choice
A 45-year-old man comes to the emergency department after experiencing sudden-onset headache with brief loss of consciousness while working in his yard. CT scan of the brain reveals blood in the basal cistern from a ruptured intracranial aneurysm. The patient is hospitalized, and endovascular coiling of the aneurysm is performed. Over the next several days, his symptoms gradually improve but the patient develops worsening hyponatremia. Which of the following is the most likely cause of this patient's hyponatremia?
A) Defective central thirst regulation
B) Impaired renal concentrating ability
C) Inadequate dietary sodium intake
D) Increased antidiuretic hormone secretion
E) Stress-induced excessive cortisol levels
G) None of the above
Correct Answer

verified
Correct Answer
verified
Multiple Choice
A 34-year-old Russian immigrant comes to the physician with a 2-month history of exertional dyspnea and progressive lower extremity swelling. He also reports abdominal distension and decreased appetite. The patient has gained 4.5 kg (10 lbs) over the last 2 months. Past medical history is significant for hypertension and recurrent lung infections requiring prolonged antibiotic therapy. He has no history of coronary artery disease. The patient has smoked a pack of cigarettes daily for the past 15 years. He undergoes noninvasive cardiac testing followed by cardiac catheterization. A jugular venous pressure tracing is shown on the slide below.  The waveform indicated by the arrow most likely corresponds to which of the following?
The waveform indicated by the arrow most likely corresponds to which of the following?
A) Atrial contraction
B) Carotid pulse upstroke
C) Isovolumetric ventricular contraction
D) Tricuspid valve closure
E) Tricuspid valve opening
G) B) and D)
Correct Answer

verified
Correct Answer
verified
Multiple Choice
A 63-year-old man comes to the emergency department due to increasing dyspnea. He was unable to mow his lawn the previous day due to shortness of breath. The patient has a history of hypertension and a 20-pack-year smoking history. He is retired and traveled to Hawaii 2 months ago. Blood pressure is 160/86 mm Hg, pulse is 94/min, and respirations are 24/min; oxygen saturation is 94% on room air. Physical examination reveals bilateral lung crackles and occasional wheezes. Laboratory testing reveals elevated brain natriuretic peptide levels. Which of the following is the primary trigger for the release of this substance in this patient?
A) Activation of alveolar juxtacapillary receptors
B) Decrease in renal perfusion pressure
C) Decrease in vena cava blood return
D) Focal myocardial necrosis
E) Increase in ventricular wall stress
F) Stretching of aortic baroreceptors
H) B) and D)
Correct Answer

verified
Correct Answer
verified
Multiple Choice
A 43-year-old woman comes to the office to discuss amenorrhea. She began having irregular menses 2 years ago, and her last menstrual period was 9 months ago. Family history is unremarkable. Laboratory studies show an increased serum prolactin level, a normal TSH level, and an undetectable β-hCG concentration. Serum calcium is normal. MRI reveals a 6-mm pituitary adenoma. The patient refuses medical and surgical therapy as she is happy about not having menstrual periods. If left untreated, this patient is at greatest risk of developing which of the following?
A) Cortical stroke
B) Gastric ulcer
C) Loss of bone mass
D) Myocardial infarction
E) Secondary diabetes mellitus
G) A) and B)
Correct Answer

verified
Correct Answer
verified
Multiple Choice
A 62-year-old woman is brought to the emergency department due to progressive weakness and dyspnea. The patient is visiting her niece, who says the patient forgot to bring her regular medications and has not been taking them for the past week. The patient began feeling weak and fatigued 3 days ago and has had shortness of breath since yesterday. Temperature is 37 C (98.6 F) , blood pressure is 122/88 mm Hg, pulse is 90/min, and respirations are 24/min and shallow. On physical examination, the patient appears dyspneic with drooping at the eyelids and corners of the mouth. Her speech has a nasal quality. Arterial blood gas obtained on room air shows pH 7.32; PaCO2 is 52 mm Hg, PaO2 is 72 mm Hg, and HCO3 is 26 mEq/L. Bedside spirometry demonstrates decreased forced vital capacity. A pathologic process involving which of the following structures is the most likely cause of this patient's shortness of breath?
A) Brain stem respiratory center
B) Muscles of respiration
C) Pulmonary arteries
D) Terminal airways and alveoli
E) Upper larger airways
G) A) and D)
Correct Answer

verified
Correct Answer
verified
Multiple Choice
The patient is started on appropriate treatment and reports significant symptom improvement. However, she now has abdominal cramping, nausea, sweating, and diarrhea. Which of the following agents can be used to effectively control these new symptoms?
A) Fluoxetine
B) Glycopyrrolate
C) Pilocarpine
D) Prazosin
E) Propranolol
G) A) and C)
Correct Answer

verified
Correct Answer
verified
Multiple Choice
A 14-year-old girl is brought to the office due to intermittent shortness of breath over the past 4 months. She is unable to link the episodes to specific events or exposures. The patient has no prior medical conditions and takes no medications. She does not smoke and has no second-hand tobacco exposure. Her family has a cat that remains indoors. There is no significant family history. Blood pressure is 110/65 mm Hg, pulse is 80/min, and respirations are 16/min. On physical examination, heart sounds are normal and the lungs are clear to auscultation. Lung function tests reveal a FEV1/FVC ratio of 83%. Which of the following would be most helpful in excluding a diagnosis of asthma in this patient?
A) Absence of peripheral blood eosinophilia
B) Negative allergy skin tests
C) Negative methacholine challenge
D) Normal chest radiography
E) Normal total serum IgE level
G) A) and B)
Correct Answer

verified
Correct Answer
verified
Multiple Choice
A 25-year-old woman comes to the hospital due to worsening dyspnea. The patient was previously healthy; 2 months ago, she delivered a healthy baby boy at 38 weeks gestation. Her arterial blood gas analysis shows evidence of hypoventilation. During further evaluation, she is asked to take several deep breaths, and the following physiologic information is obtained:  Which of the following locations is the most likely site of this patient's disease?
Which of the following locations is the most likely site of this patient's disease?
A) Brain stem
B) Nasopharynx
C) Neuromuscular junction
D) Pericardial space
E) Peripheral nerves
G) A) and B)
Correct Answer

verified
Correct Answer
verified
Multiple Choice
A 20-year-old man comes to the emergency department due to a 2-day history of increasing tiredness and exertional dyspnea. He also reports yellowish discoloration of the eyes and dark urine. The patient has no chronic medical conditions, but 5 days ago, he went to an urgent care clinic due to right leg cellulitis; a 7-day course of trimethoprim-sulfamethoxazole was prescribed. The cellulitis has improved. The patient, an exchange student from Israel, does not use tobacco, alcohol, or illicit drugs. Temperature is 37 C (98.6 F) , blood pressure is 116/76 mm Hg, and pulse is 104/min. Physical examination shows mild scleral icterus, pale oral mucous membranes, a faint systolic ejection murmur, and a nontender abdomen with no organomegaly. Hemoglobin is 7.4 g/dL and mean corpuscular volume is 90 µm3. Which of the following additional findings are most likely present in this patient?

A) A
B) B
C) C
D) D
E) E
G) All of the above
Correct Answer

verified
Correct Answer
verified
Multiple Choice
A 65-year-old woman is brought to the emergency department by her family due to worsening generalized weakness and lethargy. She has had no fever, chills, vomiting, or diarrhea but has been urinating frequently over the past several days. Her family also notes that the patient has lost 5 kg (11 lb) over the past month. She takes no medications and has smoked 1-2 packs of cigarettes daily for the last 40 years. On physical examination, the patient appears ill with dry mucous membranes. There are no abnormal lung sounds or heart murmurs. The abdomen is soft and nontender. Laboratory testing shows serum calcium of 14.0 mg/dL and normal serum glucose and urinalysis. Imaging studies reveal an 8-cm right lung mass with enlarged mediastinal lymph nodes but no focal bony lesions. Serum levels of which of the following substances are most likely to be elevated in this patient?
A) 1,25-dihydroxyvitamin D
B) ACTH
C) Parathyroid hormone (PTH)
D) Phosphorus
E) PTH-related protein
F) Thyroxine (T4)
H) A) and B)
Correct Answer

verified
Correct Answer
verified
Multiple Choice
A 2-year-old boy is brought to the clinic due to recurrent infections. Over the last year, the patient has had multiple skin and pulmonary infections requiring antibiotic therapy. Temperature is 37.2 C (99 F) , pulse is 120/min, and respirations are 20/min. The patient has silvery hair. Eye examination shows horizontal nystagmus. The oropharynx is clear, and the neck is supple. Cardiopulmonary examination is unremarkable, and the abdomen is soft. The skin appears pale with scarring from previous infections. Peripheral blood smear is shown in the image below: This patient most likely has which of the following disorders?
This patient most likely has which of the following disorders?
A) Ataxia telangiectasia
B) Chédiak-Higashi syndrome
C) Chronic granulomatous disease
D) Gaucher disease
E) Leukocyte adhesion deficiency
F) Wiskott-Aldrich syndrome
H) All of the above
Correct Answer

verified
Correct Answer
verified
Multiple Choice
A 47-year-old woman comes to the physician with progressive joint pain and swelling in her hands for the past several months. She also has easy fatigability that has gradually worsened over the same period. Morning activities are especially difficult due to stiffness lasting 1 to 2 hours after waking. Examination shows warmth, swelling, and tenderness involving the proximal interphalangeal joints, metacarpophalangeal joints, and wrists bilaterally. A blood sample is obtained for laboratory analysis. Autoantibodies against which of the following components are most specific for this patient's condition?
A) Centromeres
B) Citrullinated peptides
C) Double-stranded DNA
D) Fc portion of human IgG
E) Nuclear basic proteins
F) Phospholipids
H) C) and E)
Correct Answer

verified
Correct Answer
verified
Multiple Choice
A 34-year-old, previously healthy woman comes to the office due to irregular menstruation and a 4.5 kg (10-lb) weight gain over the past 6 months. The patient also reports muscle weakness causing difficulty climbing stairs or lifting her child. Blood pressure is 152/86 mm Hg and pulse is 72/min. BMI is 31 kg/m2. Physical examination shows excessive fat accumulation in the abdomen and supraclavicular area. Sun-exposed areas and skin creases are hyperpigmented and there are wide striae over the abdomen. Coarse hair is present on the face, chest, and abdomen. Which of the following sets of laboratory findings are most likely to be seen in this patient?

A) A
B) B
C) C
D) D
E) E
G) B) and C)
Correct Answer

verified
Correct Answer
verified
Multiple Choice
A 68-year-old woman comes to the office due to a month-long history of worsening fatigue, shortness of breath, and dry cough. The patient has symptoms that worsen with exertion and when lying flat. She has had no chest pain, palpitations, or lightheadedness. The patient has a history of hypertension and breast cancer that is in remission after surgery and doxorubicin-based chemotherapy 15 years ago. She does not use tobacco, alcohol, or illicit drugs. Blood pressure is 110/62 mm Hg and pulse is 94/min. Physical examination shows crackles at the lung bases and bilateral pedal edema. Which of the following sets of findings are most likely present in this patient?

A) A
B) B
C) C
D) D
E) E
F) F
H) B) and C)
Correct Answer

verified
Correct Answer
verified
Multiple Choice
Cellular physiologists are investigating the mechanisms of contraction cessation in cardiomyocytes in response to ischemic injury. In an animal experiment, the left anterior descending coronary artery is ligated at time 0, and changes in ATP levels within the affected myocardial cells are recorded. At which point on the graph does the affected portion of the myocardium stop contracting? 
A) A
B) B
C) C
D) D
E) E
G) B) and C)
Correct Answer

verified
Correct Answer
verified
Multiple Choice
A 7-month-old boy is brought to the physician by his parents due to irritability and white patches in his mouth. His past medical history is significant for 3 episodes of otitis media and 2 episodes of bronchiolitis that have required hospitalization. He also has a history of chronic loose stools. The child is small for his age and ill-appearing. Head and neck examination shows white patches consistent with oral candidiasis but is otherwise normal. Auscultation of the lungs shows expiratory wheezing. Cardiac examination is within normal limits. Laboratory results are as follows:  Serum protein electrophoresis shows a very low gamma globulin level. Chest x-ray reveals an absent thymic shadow. Which of the following is the most likely diagnosis?
Serum protein electrophoresis shows a very low gamma globulin level. Chest x-ray reveals an absent thymic shadow. Which of the following is the most likely diagnosis?
A) Common variable immunodeficiency
B) DiGeorge syndrome
C) Severe combined immunodeficiency
D) Wiskott-Aldrich syndrome
E) X-linked agammaglobulinemia
G) A) and D)
Correct Answer

verified
Correct Answer
verified
Multiple Choice
A 23-year-old man comes to the office due to a painful, growing lesion on his chest. The patient reports a laceration injury to the chest 6 months ago. A pink, firm plaque on examination is shown in the image below:  Which of the following is most likely responsible for this patient's lesion?
Which of the following is most likely responsible for this patient's lesion?
A) Decreased insulin-like growth factor-1 signaling
B) Decreased PDGF receptor activation on fibroblasts
C) Increased fibroblast apoptosis rate
D) Overexpression of transforming growth factor beta
E) Overproduction of matrix metalloproteinases
G) C) and E)
Correct Answer

verified
Correct Answer
verified
Multiple Choice
A 52-year-old woman comes to the office due to fatigue for the last 2 weeks. The patient was previously healthy, but over the past 3 months, she has had significant weight loss without changing her diet. She also reports increased sweating, hand tremor, and decreased sleep. Examination shows diffuse, nontender enlargement of the thyroid gland. The eyeballs are protuberant. The remainder of the examination is notable for 1+ pitting edema in the ankles. Which of the following parameters is most likely to be decreased in this patient?
A) Cardiac contractility
B) Myocardial oxygen consumption
C) Pulmonary artery pressure
D) Pulse pressure
E) Systemic vascular resistance
F) Systolic blood pressure
H) D) and F)
Correct Answer

verified
Correct Answer
verified
Multiple Choice
A 72-year-old woman is evaluated due to a month of fatigue and shortness of breath on exertion. The patient has also had lower back pain but no fever or cough. She takes valsartan for hypertension. Temperature is 37.2 C (99 F) , blood pressure is 130/80 mm Hg, pulse is 84/min, and respirations are 14/min. On physical examination, the conjunctivae are pale. The remainder of the examination is normal. Laboratory results are as follows:  X-rays of the lower back demonstrate multiple areas of radiolucency in the L4 and L5 vertebrae. Serum protein electrophoresis reveals a monoclonal gamma globulin spike. Further studies are most likely to show which of the following?
X-rays of the lower back demonstrate multiple areas of radiolucency in the L4 and L5 vertebrae. Serum protein electrophoresis reveals a monoclonal gamma globulin spike. Further studies are most likely to show which of the following?

A) A
B) B
C) C
D) D
E) E
G) B) and E)
Correct Answer

verified
Correct Answer
verified
Showing 321 - 340 of 464
Related Exams